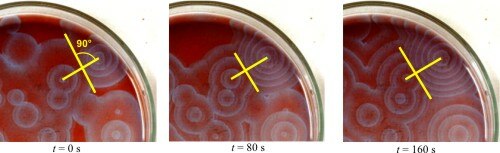

Belousov-Zhabotinsky-Reaktion

Die Belousov-Zhabotinsky-Reaktion (BZR oder BZ-Reaktion) ist das klassische Beispiel für einen homogenen chemischen Oszillator. Sie dient häufig zur Veranschaulichung emergenter und chaotischer Systeme. Es handelt sich um ein System mehrerer chemischer Reaktionen, das eine zeitliche Oszillation oder eine selbstorganisierte räumliche Struktur zeigt, abhängig von den Versuchsbedingungen, was für chemische Reaktionen eigentlich unüblich ist. Anfangs wurde die Reaktion für einen Messfehler oder Artefakt gehalten, da der zweite Hauptsatz der Thermodynamik einen solchen Vorgang zu verbieten schien. Dieser Satz der Physik besagt, dass sich aus einem ungeordneten Zustand von allein (also ohne Zufuhr externer Energie) kein geordneterer Zustand bilden kann. Dieser Satz ist hier aber nicht anwendbar, da er nur für geschlossene Systeme im thermischen Gleichgewicht gilt. Die Belousov-Zhabotinsky-Reaktion ist aber eine dissipative Reaktion,[1] die fern vom thermischen Gleichgewicht abläuft und deswegen dieses außergewöhnliche Verhalten zeigen kann.
Klassisch wird die Belousov-Zhabotinsky-Reaktion in einer Petrischale durchgeführt (siehe Abbildung rechts), weil so beispielsweise mittels Tageslichtprojektor das Muster gut zu sehen ist. Es breitet sich wie kreisförmige Wellen aus.
Das Prinzip des chemischen Oszillators lässt sich auch mit anderen Reaktionssystemen zeigen, wie mittels der sogenannten Ioduhr (Briggs-Rauscher-Reaktion).
Geschichte
Um 1950 entdeckte Boris Pawlowitsch Beloussow (Борис Павлович Белоусов, englische Transkription Belousov) die Belousov-Zhabotinsky-Reaktion eher zufällig. Er konnte bei der Oxidation von Citronensäure mit schwefelsaurer Bromatlösung und Cer-Ionen als Katalysator einen periodisch auftretenden Wechsel der Farbe der Lösung zwischen gelb und farblos beobachten. Da diese Beobachtung aus demselben Grund wie schon 1921 bei Bray zu unwahrscheinlich erschien, gelang es Beloussow erst 1959, einen kurzen Artikel darüber zu veröffentlichen. S. E. Schnoll erkannte die Bedeutung dieser Reaktion und beauftragte Anatoli Markowitsch Schabotinski (Анатолий Маркович Жаботинский, englische Transkription Zhabotinsky) mit der Untersuchung des beschriebenen Phänomens, die 1964 veröffentlicht wurde.
Langsam zeigten nicht-russische Wissenschaftler Interesse an oszillierenden Reaktionen, und eine umfassende Erforschung der mit ihnen zusammenhängenden Phänomene begann. So wurden etwa Raumstrukturen (kreisförmige Muster) entdeckt, die sich in einer dünnen Schicht einer Lösung der Belousov-Zhabotinsky-Reaktion bilden können.
1977 erhielt dann Ilya Prigogine für seine bedeutenden Forschungen auf dem Gebiet der Thermodynamik den Nobelpreis für Chemie. Er untersuchte weit vom Gleichgewicht entfernte Systeme (dissipative Strukturen), die sowohl in der Chemie (die Belousov-Zhabotinsky-Reaktion gehört zu dieser Klasse von Vorgängen) als auch in der Physik, der Biologie (wie Lotka-Volterra-Modell für Räuber-Beute-Systeme) und der Soziologie vorkommen. Nach diesem Nobelpreis wurden 1980 Beloussow (posthum), Schabotinski und mit ihnen Zaikin, Krinsky und Iwanizki gemeinsam mit dem Leninpreis, der höchsten wissenschaftlichen Auszeichnung der Sowjetunion, geehrt.
Reaktionen
An der Reaktion sind Lösungen von vier Stoffen, Kaliumbromat, Malonsäure, Kaliumbromid und konzentrierter Schwefelsäure, sowie Ferroin oder ein anderer Redoxindikator beteiligt. Bei der Reaktion wechselt der Zustand des Indikators ständig zwischen der reduzierten und der oxidierten Form, was einen typischen Farbwechsel verursacht. Bei Ferroin als Indikator wechselt die Farbe zwischen Blau (Ferriin, mit Fe3+) und Rot (Ferroin, mit Fe2+), bei Cer zwischen Gelb (Ce4+) und Farblos (Ce3+), bei Mangan zwischen Rot (Mn3+) und Farblos (Mn2+). Die Reaktion verläuft nicht beliebig lange, da sowohl Malonsäure als auch Bromat verbraucht werden.
Während der Reaktion treten drei verschiedene Prozesse (A, B, und C) mit jeweils mehreren Reaktionen auf. Prozess A ist nicht-radikalisch, der Redoxindikator ist nicht beteiligt. Im Wesentlichen wird Bromid verbraucht und zu Monobrommalonsäure umgesetzt. Während dieser Reaktion entsteht Bromige Säure, die wieder weiter umgesetzt wird.[2]
- Gesamtreaktion des Prozesses A
Ist viel Bromid verbraucht, ermöglicht dies, dass die Reaktionen des Prozesses B ablaufen können. Dieser ist radikalisch und läuft mit dem Redoxindikator ab. Bromige Säure wirkt dabei in einer ersten Reaktion als Autokatalysator (siehe Autokatalyse), wobei sich die Konzentration an Bromiger Säure pro Reaktion verdoppelt.
Bei größeren Konzentrationen an Bromiger Säure reagiert diese zu Hypobromiger Säure, so dass sich eine Gesamtreaktion für Prozess B von
ergibt.
Damit eine Oszillation möglich ist, muss es noch eine weitere Reaktion geben, bei der das verbrauchte Bromid wieder zurückgebildet wird. Dies ist der Prozess C, bei dem Malonsäure (H2Mal), Monobrommalonsäure (HBrMal), Hypobromit und der Redoxindikator unter Bromidbildung zu Tartronsäure [Hydroxymalonsäure, HOCH(COOH) 2] miteinander reagieren.
Weiteres Bromid entsteht durch die Zersetzung der Tartronsäure mit Bromat zu Kohlenstoffdioxid und Wasser.
Modell für den Reaktionsablauf
Im Folgenden soll ein einfaches Modell für die BZR geschildert werden. Das folgende Bild dient zur Veranschaulichung:
Im Anfangszustand A liegen neben den Edukten (Bromat, Malonsäure) vor allem Bromid und Ferroin in der Lösung vor. Nun kann Reaktion I ablaufen, die das Bromid verbraucht und Malonsäure bromiert. Das System geht so in den Zustand B über, in dem nahezu kein Bromid mehr vorliegt. Das Bromid hemmt schon in kleinsten Konzentrationen das Ablaufen der Reaktion II, sodass diese am Anfang keine Rolle spielt. Nun kann sie aber ablaufen und oxidiert das Ferroin, was zu einem Farbumschlag der Lösung nach blau führt. Das System befindet sich nun im Zustand C, in dem die Lösung Ferriin und kein Bromid enthält. Die Reaktion III kann nun ablaufen und reduziert das Ferriin wieder zu Ferroin, wobei auch Bromid wieder zurückgebildet wird. Außerdem entsteht noch Ameisensäure als Produkt. Dieser Zustand entspricht gerade wieder dem Ausgangszustand A.
Dieses Modell ist stark vereinfacht. Es gibt Arbeiten, in denen bis zu 20 Teilgleichungen benutzt werden, um eine sehr genaue Modellierung des Systems zu erreichen.
Mathematische Modelle

Es wurden verschiedene mathematische Modelle ausgearbeitet, um den Verlauf von chemischen Oszillatoren abzubilden. Dazu zählen:
- Brüsselator
- Oregonator[3]
Der Brüsselator ist sehr einfach, aber physikalisch unrealistisch. Er liefert aber Ergebnisse, die sehr nahe an der BZR liegen (siehe Abbildung). Außerdem ist das System relativ einfach und kann mathematisch gut analysiert werden. Oft können Modelle für die BZR mit einem zellulären Automaten simuliert werden und so werden Modelle für die räumlichen Muster in der BZR erreicht.
Strukturformeln beteiligter Substanzen
-
 Monobrommalonsäure
Monobrommalonsäure -
 Ferroin
Ferroin
Literatur
- B. P. Belousov: Eine periodische Reaktion und ihr Mechanismus. In: L. Kuhnert, U. Niedersen (Hrsg.): Selbstorganisation chemischer Strukturen. Verlag Harri Klein, Frankfurt am Main 1981, S. 73–82.
- A. M. Zhabotinsky: Eine periodische Oxydationsreaktion in flüssiger Phase. In: L. Kuhnert, U. Niedersen (Hrsg.): Selbstorganisation chemischer Strukturen. Verlag Harri Klein, Frankfurt am Main 1964, S. 83–89.
- Irving R. Epstein, Kenneth Kustin, Patrick de Kepper, Miklós Orban: Oszillierende chemische Reaktionen. In: Spektrum der Wissenschaft., Nr. 5, 1983, S. 98–107.
- Richard J. Field: Das Experiment: Eine oszillierende Reaktion. In: Chemie in unserer Zeit. 7, Nr. 6, 1973, S. 171–176,
doi:
 10.1002/ciuz.19730070603.
10.1002/ciuz.19730070603. - Richard J. Field, Friedmann W. Schneider: Oszillierende chemische Reaktionen und nichtlineare Dynamik. In: Chemie in unserer Zeit. 22, Nr. 1, 1988, S. 17–29,
doi:
 10.1002/ciuz.19880220104.
10.1002/ciuz.19880220104. - Ulrich F. Franck: Chemische Oszillationen. In: Angewandte Chemie. 90, Nr. 1, 1978, S. 1–16,
doi:
 10.1002/ange.19780900104.
10.1002/ange.19780900104. - Jearl Walker: Oszillierende chemische Reaktionen. In: Spektrum der Wissenschaft. 5, Nr. 231, 1980, S. 131–137.
Weblinks
- Jan Krieger:
 Oszillierende Chemische Reaktionen am Beispiel der Belousov-Zhabotinsky-Reaktion. 5. Mai 2001
(Facharbeit im Bundeswettbewerb Jugend forscht 2001).
Oszillierende Chemische Reaktionen am Beispiel der Belousov-Zhabotinsky-Reaktion. 5. Mai 2001
(Facharbeit im Bundeswettbewerb Jugend forscht 2001). - Video:
 Die Zhabotinsky-Reaktion als Modell einer Musterbildung. Institut für den Wissenschaftlichen Film (IWF) 1983, zur Verfügung gestellt
von der Technischen Informationsbibliothek (TIB),
doi:
Die Zhabotinsky-Reaktion als Modell einer Musterbildung. Institut für den Wissenschaftlichen Film (IWF) 1983, zur Verfügung gestellt
von der Technischen Informationsbibliothek (TIB),
doi:  10.3203/IWF/C-1473.
10.3203/IWF/C-1473.
Einzelnachweise
- ↑ Ilya Prigogine: Vom Sein zum Werden – Zeit und Komplexität in den Naturwissenschaften, Piper 1992.
- ↑ Richard J. Field, Friedmann W. Schneider: Oszillierende chemische Reaktionen und nichtlineare Dynamik. In: Chemie in unserer Zeit. 22, Nr. 1, 1988, S. 17–29,
doi:
 10.1002/ciuz.19880220104.
10.1002/ciuz.19880220104.
- ↑ Richard J. Field, Richard M. Noyes: Oscillations in chemical systems. IV. Limit cycle behavior in a model of a real chemical reaction. In:
The Journal of Chemical Physics. 60, Nr. 5, 1974, S. 1877–1884,
doi:
 10.1063/1.1681288.
10.1063/1.1681288.


© biancahoegel.de
Datum der letzten Änderung: Jena, den: 08.05. 2026
